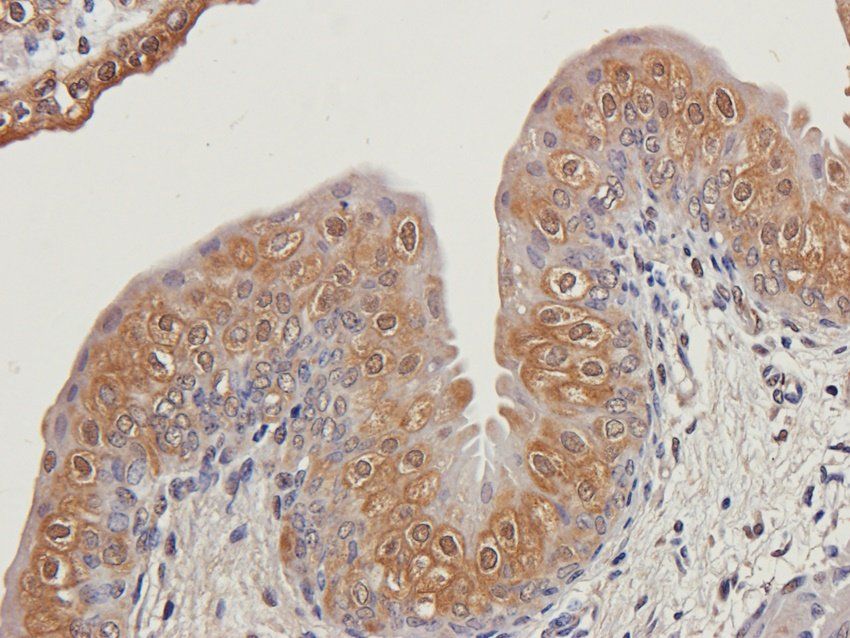
C5b-9 antibody

You have no items in your shopping cart.
All Products
- SSBP1 Rabbit Polyclonal Antibody [orb1676266]
ELISA, FC, ICC, IF, IHC, WB
Human
Rabbit
Polyclonal
Unconjugated
100 μg - PACSIN2 Rabbit Polyclonal Antibody [orb1676243]
ELISA, FC, ICC, IF, IHC, WB
Human, Monkey, Mouse, Rat
Rabbit
Polyclonal
Unconjugated
100 μg - RPS5 Rabbit Polyclonal Antibody [orb1676360]
ELISA, FC, ICC, IF, IHC, WB
Human, Mouse, Rat
Rabbit
Polyclonal
Unconjugated
100 μg - Androgen Receptor Antibody [orb18847]
ChIP, ELISA, IF, IHC, WB
Human
Bovine, Canine, Mouse, Porcine, Rat
Goat
Polyclonal
Unconjugated
100 μg - Adipogenesis Marker Antibody Panel [orb3130888]
IF, IHC, WB
Human, Mouse, Rat
Unconjugated
1 kit (5 x 25 μl) - Featured
C5b-9 antibody [orb100655]Featured
ICC, IF, IHC-P
Guinea pig, Mouse, Rat
Rabbit
Polyclonal
Unconjugated
100 μg - Hsp90 beta/HSP90AB1 Rabbit Polyclonal Antibody [orb315144]
ICC, IF, IHC, WB
Human, Mouse, Rat
Rabbit
Polyclonal
Unconjugated
100 μg